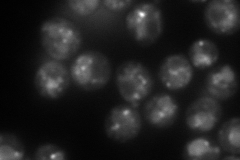
YEL042W
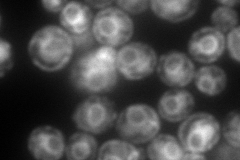
YEL042W
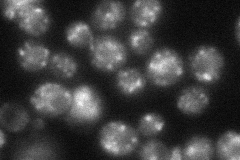
YEL042W
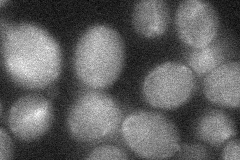
YEL042W

View description
Guanosine diphosphatase located in the Golgi, involved in the transport of GDP-mannose into the Golgi lumen by converting GDP to GMP after mannose is transferred its substrate
Localization:
Intensity:
Fold change:
Significance:
-
C’ GFP library in SD

punctate28.89 -
N' NOP1pr-GFP in SD
punctate,vacuole143.445 -
N' TEF2pr-mCherry in SD
ER223.992 -
N' NATIVEpr-GFP in SD
punctate70.2282 -
N' TEF2pr-VC and Cyto-VN in SD
below threshold26.6081 -
C’ GFP library in SD+DTT

punctate15.420.53Yes -
C’ GFP library in SD+H2O2

punctate18.660.64Yes -
C’ GFP library in Starvation Media

punctate21.630.74No -
C’ GFP library on the background of Pup2-DaMP

punctate -
C’ GFP library on the background of CCT mutant

punctate19.56160.676951Yes
